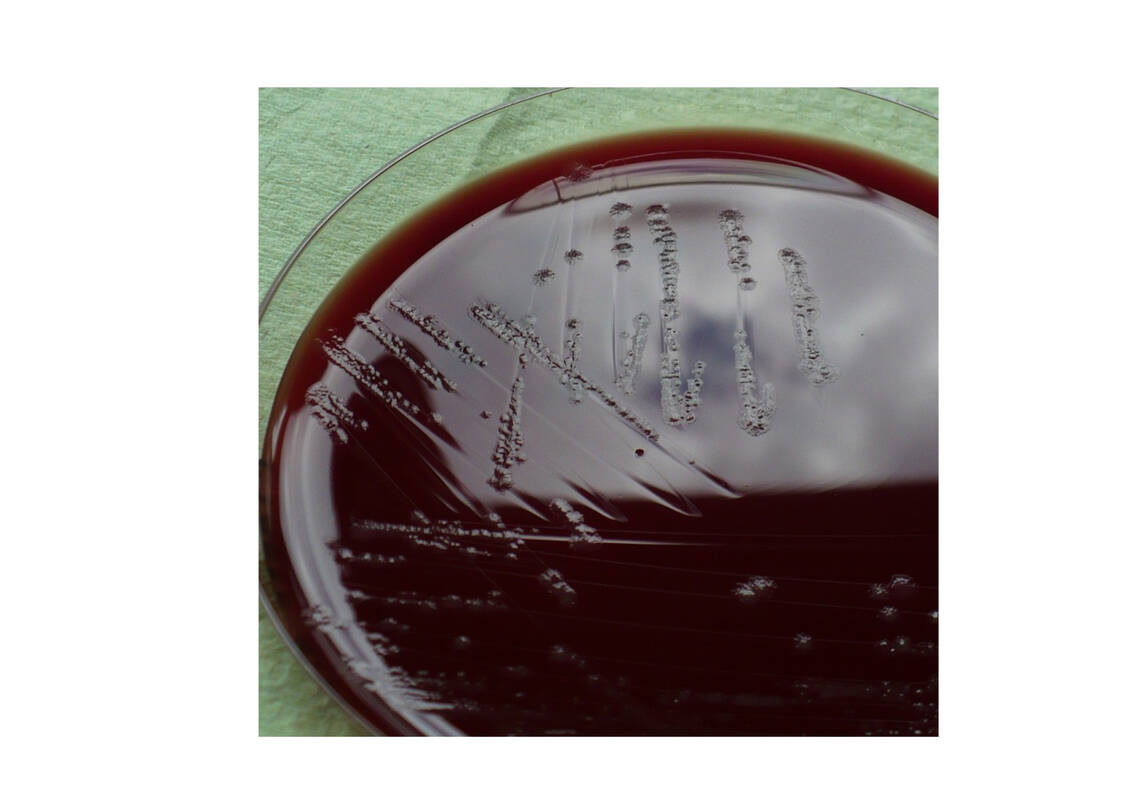
x_abb_1_folie1.jpg

Eine akut einsetzende Durchfallerkrankung ist ein unvorhergesehenes und unangenehmes Ereignis. Oft ist zu Beginn der Symptome nicht klar, ob es sich um eine nichtinfektiöse oder infektiöse Erkrankung handelt. So ist etwa eine nichtinfektiöse Antibiotika-assoziierte Diarrhö von einer Erkrankung mit dem sporenbildenden Bakterium Clostridioides difficile zu unterscheiden. Der Autor erläutert Therapie und Hygienemaßnahmen.
Für Durchfallerkrankungen von Patientinnen und Patienten (im Folgenden: Patienten) auf der Intensivstation können insgesamt vier verschiedene Ursachenkomplexe vorliegen, die diagnostisch voneinander abzugrenzen sind (Tab. 1).
Es handelt sich einerseits um nichtinfektiöse, medikamentöse, ernährungs- oder durchblutungsbedingte Reaktionen des Darmes auf Schädigungen. Andererseits können jedoch auch infektiöse Durchfälle eine Rolle spielen. Deren häufigster Erreger ist der sporenbildende Toxinbildner Clostridioides difficile.
Art und Zeitpunkt des Auftretens der Symptomatik sind wegweisend
Klinisch ist es wichtig, die Symptomatik zunächst im Einzelnen zu erfassen, um infektiöse von nichtinfektiösen Ursachen abzugrenzen. Hierfür sind folgende Befunde zu erheben:
- Ist der Durchfall nach dem Beginn einer Sondenernährung des Patienten aufgetreten?
- Ist kurz zuvor eine systemische Antibiotikatherapie begonnen worden?
- Ist der Stuhl lediglich breiig oder gab es frische (hellrote) Blutbeimengungen?
- Enthält der Stuhl altes, schwärzlich gefärbtes, geronnenes Blut?
- Hat der Patient neben der Durchfallerkrankung Fieber entwickelt?
- Ist das Abdomen trommelförmig aufgetrieben?
- Sofern der Patient bei Bewusstsein und nicht stark sediert ist: Besteht ein Druckschmerz in bestimmten Bauchbereichen?
- Besteht eine Abwehrspannung der Bauchdecke?
- Hat der Patient eine an der Haut erkennbare Blutungsneigung?
- Besteht ein hypersonorer Klopfschall bei der Perkussion?
Zusätzlich zu diesen klinischen Befunden sollte laborchemisch nach einem Anstieg der Leukozytenzahl, einer Erhöhung des C-reaktiven Proteins (CRP) und einer Erhöhung des Procalcitonin-(PCT-)Werts gefahndet werden. Abweichungen dieser Parameter nach oben lenken den Verdacht auf eine infektiöse Ursache. Zur Basisdiagnostik gehört auch eine Ultraschalluntersuchung des Abdomens, bei der auch nach freier Luft und Ergüssen im Abdomen zu fahnden ist.
Nichtinfektiöse Folge einer Antibiotikatherapie
Jede breit wirksame Antibiotikatherapie schädigt die normale Darmflora und kann dadurch Bauchschmerzen, Krämpfe und Durchfälle auslösen. Dabei muss nicht immer der Erreger Clostridioides (C.) difficile eine Rolle spielen. Vielmehr kann eine Diarrhö auch ohne spezielle Erregerbeteiligung entstehen, wenn die normale Darmflora so vermindert und/oder in ihrer Zusammensetzung gestört ist, dass mit der Nahrung zugeführte Eiweißstoffe und Zucker nicht mehr vorverdaut werden. Die Fachbezeichnung hierfür lautet nichtinfektiöse Antibiotika-assoziierte Diarrhö (AAD).
Leider haben klinische Versuche, parallel zu einer Antibiotikatherapie auf der Intensivstation die Darmflora durch Gabe von Probiotika zu stabilisieren, sehr variable Ergebnisse erbracht, sodass sich in der Summe keine evidenzbasierte Empfehlung dafür aussprechen lässt. Es bleibt lediglich die Möglichkeit, die Indikation für eine Antibiotikatherapie streng zu stellen und möglichst schmal wirksame Antibiotika auszuwählen, die ausschließlich auf den vermuteten oder nachgewiesenen Erreger ausgerichtet sind. Dabei ist auch darauf zu achten, möglichst Antibiotika zu verwenden, die nicht in aktiver Form über die Gallenwege in den Darm ausgeschieden werden. Zu bevorzugen sind zumindest bei nierengesunden Patienten Substanzen, die über die Nieren eliminiert werden.
Clostridioides-difficile-Infektion (CDI)
Sofern aus der Anamnese weder ein Morbus Crohn noch eine Colitis ulcerosa bekannt sind und keine Hinweise für eine Darmischämie vorliegen, ist eine Diagnostik auf C. difficile sinnvoll. Hierzu ist eine durchfällige Stuhlprobe von etwa zwei Millilitern Volumen ins mikrobiologische Labor zu senden. Laut einer klinischen Dissertationsarbeit aus dem Jahr 2018 passiert leider häufig der Fehler, dass an einem Tag mehrere Stuhlproben das Labor erreichen, das diese dann unnötigerweise auch untersucht [1]. Dies führt zu höheren Kosten.
Es hat sich gezeigt, dass für die Erstdiagnostik ein einmaliger Test auf das Enzym Glutamatdehydrogenase (GDH) ausreicht. Dieser relativ günstige Test prüft, ob dieses Enzym in der Stuhlsubstanz nachzuweisen ist. Ein entsprechend positives Ergebnis ist meist ein Hinweis darauf, dass ein C.-difficile-Stamm im Stuhl vorhanden ist. Damit ist allerdings noch nicht die Frage beantwortet, ob dieser Erreger auch die für die Auslösung der Erkrankung erforderlichen Giftstoffe Toxin A und/oder Toxin B bildet.
Bei positivem GDH-Test wird daher im Labor automatisch ein spezifischer Test auf das Toxin B nachgezogen, das bei allen krankheitsauslösenden C.-difficile-Stämmen vorhanden ist. Seit wenigen Jahren dient dazu in den meisten Laboren ein Gennachweis des Toxin-B-Gens mittels Polymerase-Kettenreaktion (PCR).
Wenn gewünscht, kann das Labor auch eine Stuhlkultur auf C. difficile auf einem Spezialagar anlegen. Der Erreger lässt sich dann z. B. zur Analyse von nosokomialen Übertragungsketten molekular typisieren (Abb. 1).
Vorgehen nach CDI-Nachweis. Die Kommission für Krankenhaushygiene und Infektionsprävention beim Robert Koch-Institut hat empfohlen, dass bereits dann, wenn der Verdacht auf eine CDI geäußert und eine Stuhlprobe auf C. difficile eingesandt wird, eine vorsorgliche Isolierung des Patienten im Einzelzimmer vorzunehmen ist [2]. Isolierung bedeutet in diesem Fall, das Infektionszimmer ist nur mit Schutzkittel und Einmalhandschuhen zu betreten. Für die tägliche Flächendesinfektion ist ab diesem Zeitpunkt ein sporenabtötendes Mittel zu verwenden, denn C. difficile bildet nach Verlassen des Darmes sehr schnell Sporen aus. Diese verteilen sich leicht durch Handkontakte im Infektionszimmer.
Eine Studie aus England, die Abstriche in mehreren C.-difficile-Isolierzimmern gewann, zeigte, dass v. a. häufig berührte Flächen, aber auch der Putzwagen selbst den Erreger beherbergen (Abb. 2).
Daher ist unbedingt das gesamte Zimmer sporizid zu desinfizieren. In den USA kommt als sporenabtötendes (sporizides) Mittel meist Natriumhypochlorit zum Einsatz, das allerdings keine reinigenden Eigenschaften besitzt. In Deutschland stehen im Handel mehrere sauerstoffabspaltende Produkte auf Peressigsäurebasis zur Verfügung, die zusätzlich auch reinigende Tenside enthalten. Die Hygienefachperson sollte daher das Reinigungspersonal schulen, damit dieses die kritischen Flächen vollständig erfasst.
Therapie der CDI. Therapeutisch ist bei positivem C.-difficile-Test umgehend ein gegen den Erreger wirksames Antibiotikum peroral bzw. über die Magensonde zu applizieren – in erster Linie klinisch das Vancomycin, da es am preiswertesten ist und Resistenzen nahezu nicht vorkommen. Dosis: viermal täglich 125 mg, sodass die Tagesgesamtdosis 500 mg beträgt.
Als gleichwertig gilt das neuere Präparat Fidaxomicin, das jedoch wesentlich teurer ist. Es wird daher meist erst bei Auftreten eines Rezidivs verordnet. Fidaxomicin besitzt allerdings den Vorteil, dass es wesentlich besser gegen die Sporenform von C. difficile wirkt, wodurch auch die Umgebungsbelastung mit Sporen des Erregers sinkt [4, 5].
Im Rahmen einer kürzlich in England veröffentlichten Studie erhielten 253 Patienten mit nachgewiesener CDI eine Behandlung mit verschiedenen Antibiotika. Unter der Therapie wurden 3.174 Umgebungsabstriche im Isolierzimmer gewonnen. Es zeigte sich ein signifikanter Vorteil bezüglich der Umgebungsbelastung für die Therapie mit Fidaxomicin (Abb. 3).
Abbildung 3 lässt aber auch erkennen, dass bei Therapieende immer noch zwischen 20 und 45 Prozent der Umgebungsproben erregerpositiv sind, sodass unbedingt bei Therapieende eine gründliche sporizide Wischdesinfektion des gesamten Zimmers vorzunehmen ist.
Ist die Therapie beendet und der Patient mindestens 48 Stunden durchfallfrei, kann die Isolierung enden. Der Patient sollte zu diesem Zeitpunkt ein frisches Bett erhalten und in ein anderes Zimmer verlegt werden, um das Isolierzimmer intensiv zu desinfizieren.
Herrn Prof. Dr. med. Matthias Trautmann, Neu-Ulm danke ich für die Durchsicht und Diskussion.
[1] Mayer BE. Diagnostik der Clostridium-difficile-Infektion. Klinische Konsequenzen der Umstellung auf eine PCR-basierte Diagnostik. Dissertation, Universität Ulm, 2018
[2] Kommission für Krankenhaushygiene und Infektionsprävention beim Robert Koch-Institut. Hygienemaßnahmen bei Clostridioides-difficile- Infektion (CDI). Bundesgesundheitsbl 2019; 62: 906–923
[3] Hill KA et al. Comparison of two selective media for recovery of Clostridium difficile from environmental surfaces. J Hosp Infect 2013; 83: 164–166
[4] Turner NA et al. Impact of oral metronidazole, vancomycin, and fidaxomicin on host shedding and environmental contamination with Clostridioides difficile. Clin Infect Dis 2022; 74: 648–656
[5] Davies K et al. An analysis of Clostridium difficile environmental contamination during and after treatment for C. difficile infection. Open Forum Infectious Diseases 2020. DOI:10.1093/ofid/ofaa362